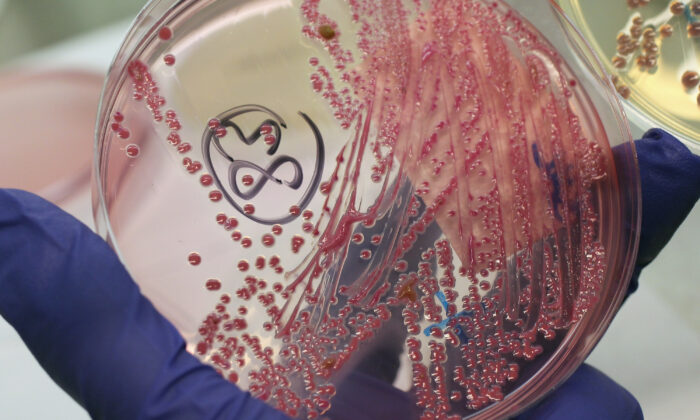

Правительство Гамбии расследует, связана ли смерть десятков маленьких детей от почечной недостаточности в последние месяцы с сиропом парацетамола, заявил в четверг глава службы здравоохранения страны.
Всплеск случаев острого повреждения почек среди детей в возрасте до пяти лет был выявлен в конце июля. По мере роста числа случаев врачи начали подозревать, что в этом могут быть замешаны лекарства.
Директор службы здравоохранения Гамбии Мустафа Биттайе агентству Reuters, что несколько пациентов начали болеть с проблемами почек через 3-5 дней после приема сиропа парацетамола, который продается в стране. Пока не ясно, ведется ли расследование в отношении какой-то конкретной марки парацетамола.
По словам Биттайе, возможной причиной также является бактерия кишечной палочки.
Симптомы, от которых страдали дети, включают неспособность выводить мочу и лихорадку, которая в течение нескольких часов может привести к почечной недостаточности.
По данным министерства здравоохранения, к началу августа умерло 28 детей, что составляет почти 90 процентов смертности. По словам Биттайе, число смертельных случаев сейчас намного выше.
Официальные обновленные данные ожидаются в ближайшие дни.
“За последние три месяца умерли десятки детей”, — сказал Биттайе агентству Reuters по телефону. “Вскрытия показывают, что причиной смерти мог стать парацетамол”.
В заявлении, сделанном на прошлой неделе, органы здравоохранения отметили, что у такого рода заболеваний часто бывает более одной причины.
Бактерии кишечной палочки также могут быть возможной причиной, поскольку в последние недели сильные дожди вызвали наводнения в Гамбии и во многих странах Западной Африки. Неасфальтированные улицы столицы Банжула и близлежащих городов были переполнены.
По словам работников здравоохранения, использование открытых выгребных ям и открытых питьевых колодцев в городских центрах может привести к загрязнению питьевой воды и способствовать распространению заболеваний, передающихся через воду, таких как кишечная палочка.